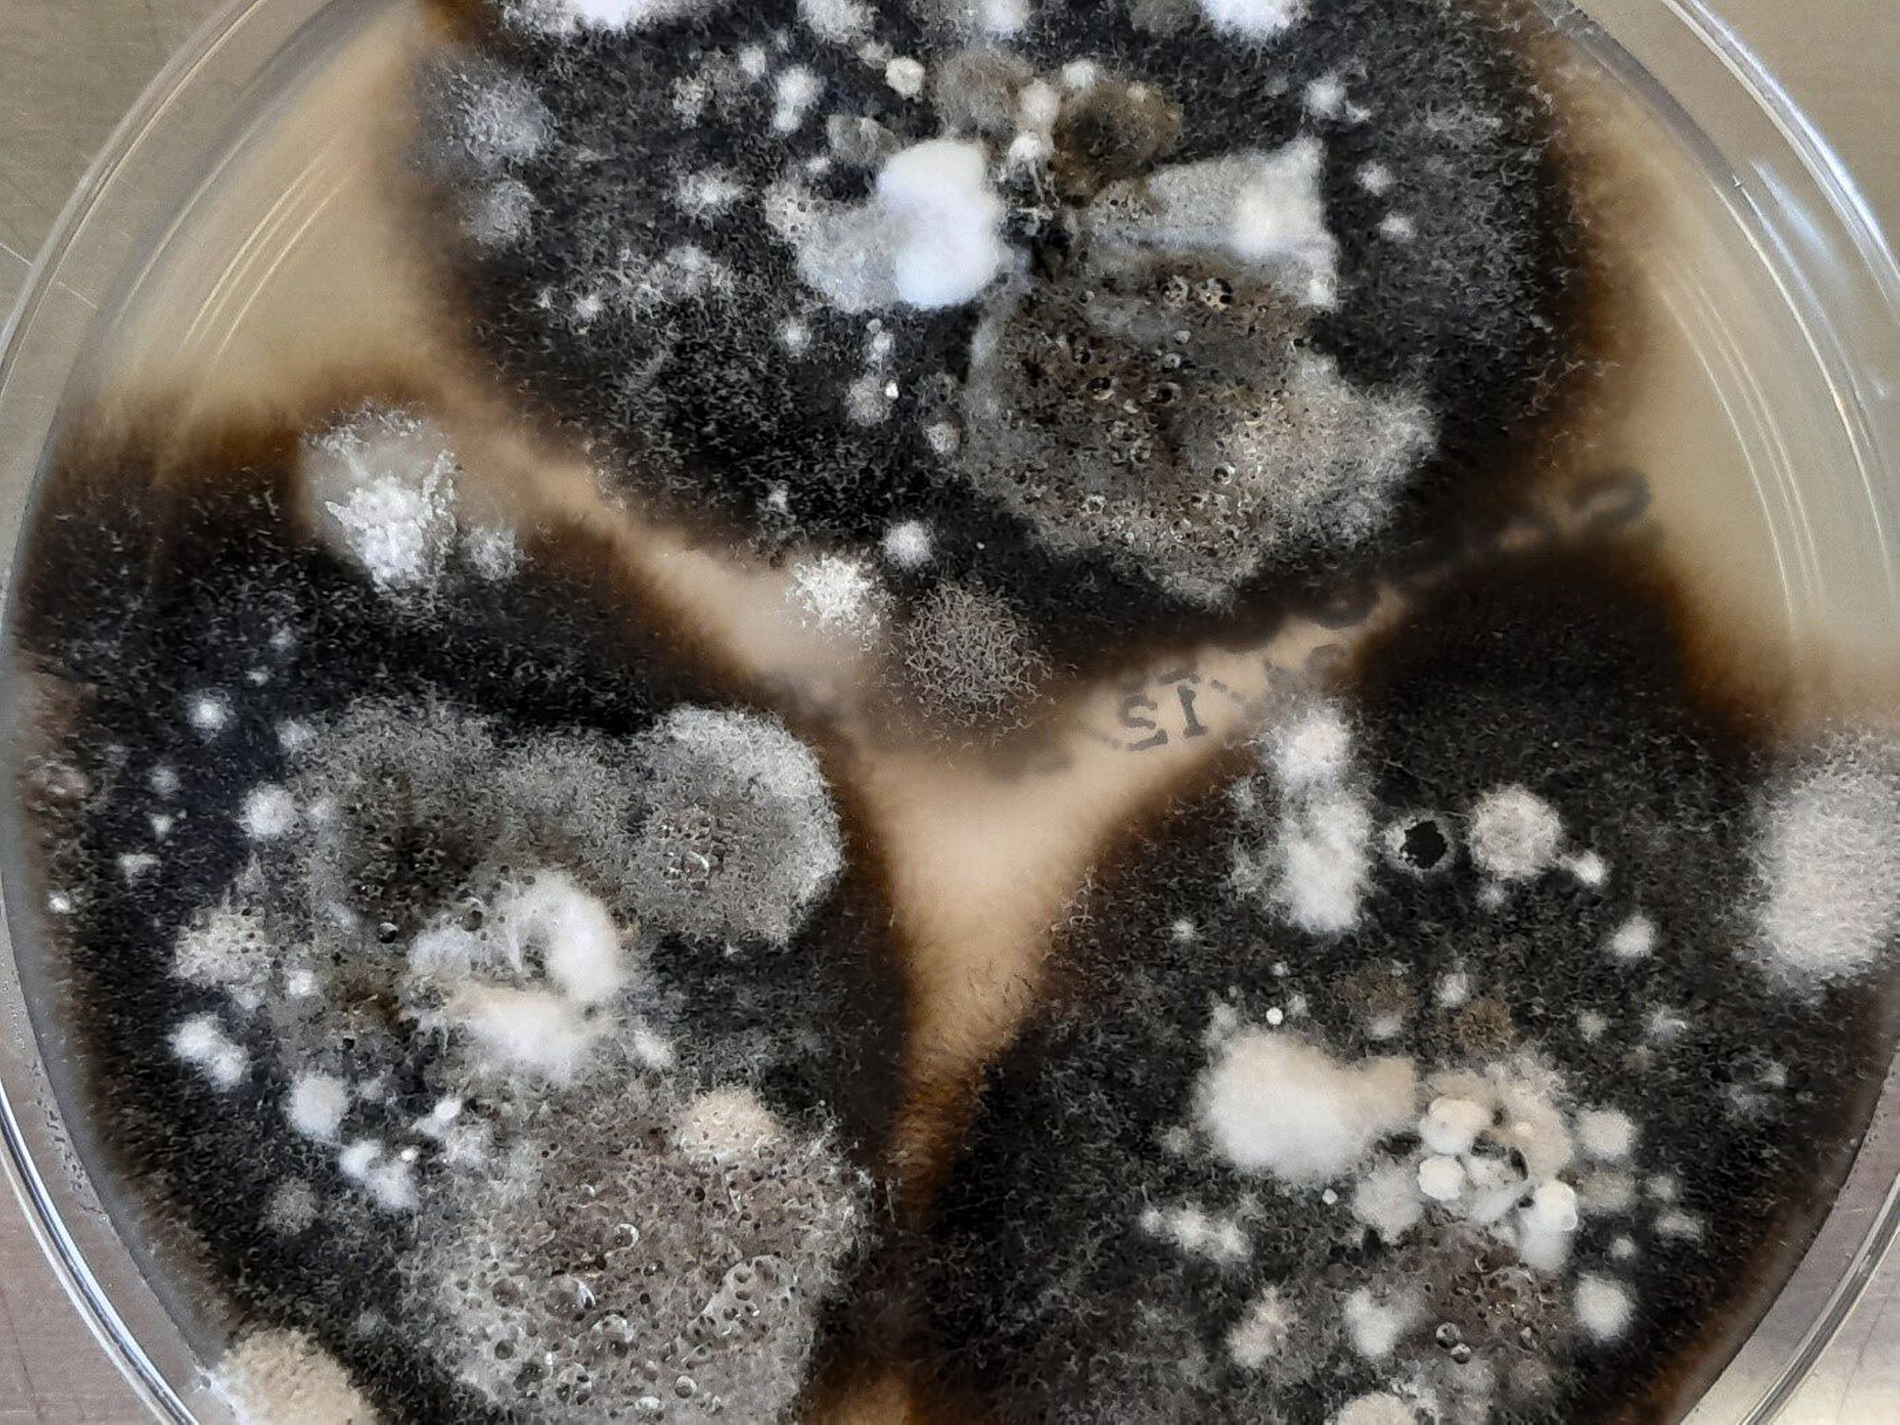

Invasive Mykose mit ossärer Destruktion der Nasennebenhöhlen
Im Juli 2024 stellte sich eine 59-jährige Frau notfallmäßig mit Schmerzen im linken Oberkiefer mit begleitender Schwellung am Unterlid in der MKG-Ambulanz vor. Die Patientin gab an, dass vor mehreren Jahren eine Wurzelkanalbehandlung am Zahn 26 durchgeführt worden sei. Gewalteinwirkungen auf den Schädel durch Sturz oder Trauma sowie eine Tumoranamnese wurden verneint.
Klinisch imponierte eine deutliche Schwellung am linken Unterlid ohne Visus- und Sensibilitätsstörungen. Im Rahmen der intraoralen Inspektion zeigte sich ein verstrichenes Vestibulum an der Crista zygomaticoalveolaris links mit deutlichem Palpationsschmerz über der fazialen Kieferhöhlenwand. Die computertomografische Untersuchung zeigte eine vollständige Verlegung des linken Sinus maxillaris mit knöchernen Arrosionen der Kieferhöhlenvorderwand, medialen Kieferhöhlenwand, der Ethmoidalzellen und Infiltration des Orbitabodens sowie Einbruch in das Subkutangewebe der Wange (Abbildung 1).
Nach ausführlicher Besprechung der Befunde und Therapiemöglichkeiten führten wir eine Exploration der linken Kieferhöhle über einen transantralen Zugang mit Fensterung des Sinus maxillaris zum unteren Nasengang sowie eine Wurzelspitzenresektion an den drei apikal beherdeten Wurzeln des Zahns 26 in Allgemeinnarkose durch. Intraoperativ konnte aus der linken Kieferhöhle reichlich schwarzes Gewebe mit Pus exkaviert werden. Ersteres war gut vereinbar mit einer Pilzinfektion. Bei der Wurzelspitzenresektion waren intraoperativ keine Pilzanteile sichtbar. In der histopathologischen Untersuchung zeigte sich ein tumorbildendes Pilzproliferat aus Mycelien mit chronisch granulozytärer Sinusitis und Osteomyelitis. Die mikrobiologische Untersuchung ergab den Nachweis von Lomentospora prolificans (Abbildung 2).
Zum Ausschluss eines disseminierten Pilzbefalls wurden in der MRT-Bildgebung vom Schädel und der computertomografischen Untersuchung vom Thorax und Abdomen sanierungsbedürftige Filiae ausgeschlossen. Die konsiliarisch durchgeführte augenärztliche Untersuchung ergab keinen Hinweis auf eine intraokulare Beteiligung. Der weitere postoperative Verlauf gestaltete sich komplikationslos mit stadiengerechter Wundheilung (Abbildung 3).
In enger Zusammenarbeit mit der Klinik für Innere Medizin/Klinische Infektiologie am Universitätsklinikum Köln begannen wir eine antimykotische Therapie mit Voriconazol 200 Milligramm (1-0-1) und Terbinafin 250 Milligramm (1-0-1) per os. Im Rahmen der Weiterbehandlung wurde bei nachgewiesener Resistenz für Voriconazol sowie weitere Antimykotika ein individueller Heilversuch mit Fosmanogepix eingeleitet. Ein Kontroll-CT im Abstand von acht Wochen zeigte ein gutes Ansprechverhalten ohne erneute Beschwerden.
Diskussion
Die Inzidenz von invasiven Mykosen nimmt weltweit zu, daran sterben pro Jahr rund 2,5 Millionen Menschen [Denning, 2024]. Näherungsweise erkranken jährlich über zehn Prozent aller Deutschen an Pilzinfektionen [Ruhnke et al., 2015]. Dabei überwiegen oberflächliche Haut- und Nagelmykosen. Erstmals wurden Aspergillus-Infektionen am Ende des 19. Jahrhunderts nachgewiesen [Schubert, 1885]. Neben der Aspergillose zählen inzwischen die Candidose und die Mukormykose zu den häufigsten fakultativ pathogenen Pilzen.
Durch die bildgebenden Verfahren gelingt es häufiger, Mykosen der Nasennebenhöhlen zu erkennen und damit auch seltene Mykosen wie Lomentospora prolificans zu bestimmen. Mitte der 1980er Jahre wurde Lomentospora prolificans das erste Mal bei einer Osteomyelitis nachgewiesen [Malloch und Salkin, 1985]. Hierbei handelt es sich um eine ubiquitär vorkommende Schimmelpilzart, die hauptsächlich im Erdreich und in Gewässern vorkommt. Lomentospora prolificans ist ein opportunistischer Erreger, der bei immunsupprimierten und immunkompetenten Menschen und Tieren eine Vielzahl von Infektionen verursacht [Cortez et al., 2008].
Durch die Inhalation von Sporen gelangen die Erreger häufig in die Nase. Als Verletzungsmykose können sie auch durch traumatische Inokulation von infektiösem Material auftreten. Im zahnmedizinischen Praxisalltag können Mund-Antrum-Verbindungen infolge von endodontischen und dentoalveolären Eingriffen eine mögliche Eintrittspforte für invasive Pilzerreger darstellen. Bei der Patientin ergab der histopathologische Befund der Wurzelspitzenresektion keinen Pilznachweis. Eine odontogene Ursache konnte in diesem Fall somit ausgeschlossen werden.
Die klinische Symptomatik ist oft unspezifisch und kann einen asymptomatischen Verlauf bis zu einer Palpations- und Perkussionsempfindlichkeit der Nasenebenhöhlen mit Behinderung der Nasenatmung und Rhinorrhoe umfassen. Weitere Hinweise auf eine invasive Pilzinfektion können in konventionellen Röntgenaufnahmen wie der Panoramaschichtaufnahme oder in der digitalen Volumentomografie sichtbar werden. Häufig liegt eine punktförmige, metalldichte Opazität in der Kieferhöhle vor, wobei typischerweise nur eine Kieferhöhle betroffen ist.
Neben der Pathogenität der Schimmelpilzerreger ist für die Ausdehnung der mykotischen Infektion der Immunstatus des Patienten von Bedeutung. Der Schweregrad der Infektion reicht von leichten lokalen Infektionen bis hin zu schweren disseminierten Fällen. Im vorliegenden Fall lag bei einer immunkompetenten Patientin eine lokal destruktive Ausbreitung der mykotischen Infektion mit Infiltration benachbarter Nasennebenhöhlen und Orbita vor.
Eine invasive Mykose der Keilbeinhöhle mit Infiltration der Orbita durch Lomentospora prolificans kann auch bei einem immunkompetenten Patienten zu Gesichtsfeldausfällen mit Motilitätseinschränkungen des Bulbus führen [Kakuno et al., 2023]. Invasive Schimmelpilzinfektionen sind bei malignen hämatologischen Erkrankungen und bei Patienten mit Stammzelltransplantation mit einer hohen Morbiditäts- und Mortalitätsrate verbunden [Blyth et al., 2014]. Lomentospora prolificans induzierte Mykosen mit disseminiertem Befall haben eine Mortalitätsrate von mehr als 77 Prozent [Jenks et al., 2020].
Die Therapie einer invasiven Mykose im Bereich der Nasennebenhöhlen ist abhängig von der klinischen Verlaufsform und setzt sich aus einem abgestuften medikamentösen und chirurgischen Behandlungsschema zusammen. Die chirurgische Behandlung besteht naturgemäß in einer vollständigen Ausräumung der veränderten Schleimhaut und des infiltrierten Knochens. Im vorliegenden Fall fand bei ausgedehnter ossärer Destruktion mit Infiltration von knöchernen Nachbarstrukturen und umliegendem Weichgewebe eine selektive Ausräumung des erkrankten Gewebes statt. Gleichzeitig ist eine intensive medikamentöse Behandlung mittels Antimykotika erforderlich.
Fazit für die Praxis
Lomentospora prolificans ist ein opportunistischer Erreger einer invasiven Mykose der Nasennebenhöhlen, die bei disseminierter Ausbreitung aufgrund multipler Antimykotika-Resistenzen eine hohe Mortalität aufweist.
Im zahnärztlichen Röntgen kann eine einseitige metalldichte Opazität innerhalb der Kieferhöhle hinweisgebend für eine Pilzinfektion sein.
Die Therapie soll interdisziplinär erfolgen und setzt sich aus einem medikamentösen und chirurgischen Behandlungsschema zusammen.
Engmaschige klinische und radiologische Verlaufskontrollen sind zur Beurteilung der Dauer von Antimykotika zwingend indiziert.
Für eine erfolgreiche Therapie stellt dabei die intrinsische Resistenz von Lomentospora prolificians gegen fast alle derzeit verfügbaren und zugelassenen Antimykotika ein großes Problem dar [Lackner et al., 2014]. Die antimykotische Therapie der Patientin wurde deshalb mit Fosmanogepix fortgeführt. Fosmanogepix ist ein neuartiges Antimykotikum, das in einer Phase II-Studie getestet wurde und zur Behandlung von invasiven Mykosen durch Candida, Aspergillus und seltenen Schimmelpilzen eingesetzt wird [Shaw und Ibrahim, 2020]. Im Rahmen der Nachsorge müssen Ansprechen und Dauer der antimykotischen Therapie engmaschig klinisch und radiologisch überprüft werden.
Literaturliste
Blyth CC, Gilroy NM, Guy SD, et al. (2014) Consensus guidelines for the treatment of invasive mould infections in heamtological malignancy and haemopoietic stem cell transplantation. Internal Medicine Journal 44(12b): 1333-1349.
Cortez KJ, Roilides E, Quiroz-Telles F, et al. (2008) Infections caused by Scedosporium spp. Clinical Microbiology Reviews 21(1): 157–197
Denning DW (2024) Global incidence and mortality of severe fungal disease. The Lancet Infectious Diseases 24(7): 428-438.
Kakuno S, Imoto W, Teranishi Y, Kakeya H (2023) Lomentospora prolificans – induced Invasive Fungal Sinusitis. Internal Medicine Advance Publication 62(18): 2761-2762.
Jenks JD, Seidel D, Cornely OA, et al. (2020) Clinical characteristics and outcomes of invasive Lomentospora prolificans infections. Analysis of patients in the FungiScope registry. Mycoses 63(5): 437-442.
Lackner M, Hagen F, Meis JF, et al. (2014) Susceptibility and Diversity in the Therapy-Refractory Genus Scedosporium. Antimicrobial Agents and Chemotherapy 58(10): 5877–5885.
Malloch D, Salkin IF (1984) A new species of Scedosporium associated with osteomyelitis in humans. Mycotaxon 21(12): 247-55.
Ruhnke M, Groll AH, Mayser P, et al. (2015) Estimated burden of fungal infections in Germany. Mycoses 58(5):22-28.
Schubert P (1885) Fadenpilze in der Nase. Berliner Klinische Wochenschrift 26: 856.
Shaw KJ, Ibrahim AS (2020) Fosmanogepix: A Review of the First-in-Class Broad Spectrum Agent for the Treatment of Invasive Fungal infections. Journal of Fungi 6: 239.
Zarniko C (1891) Aspergillusmykosen der Kieferhöhle. Deutsche Medizinische Wochenzeitschrift 17: 222.